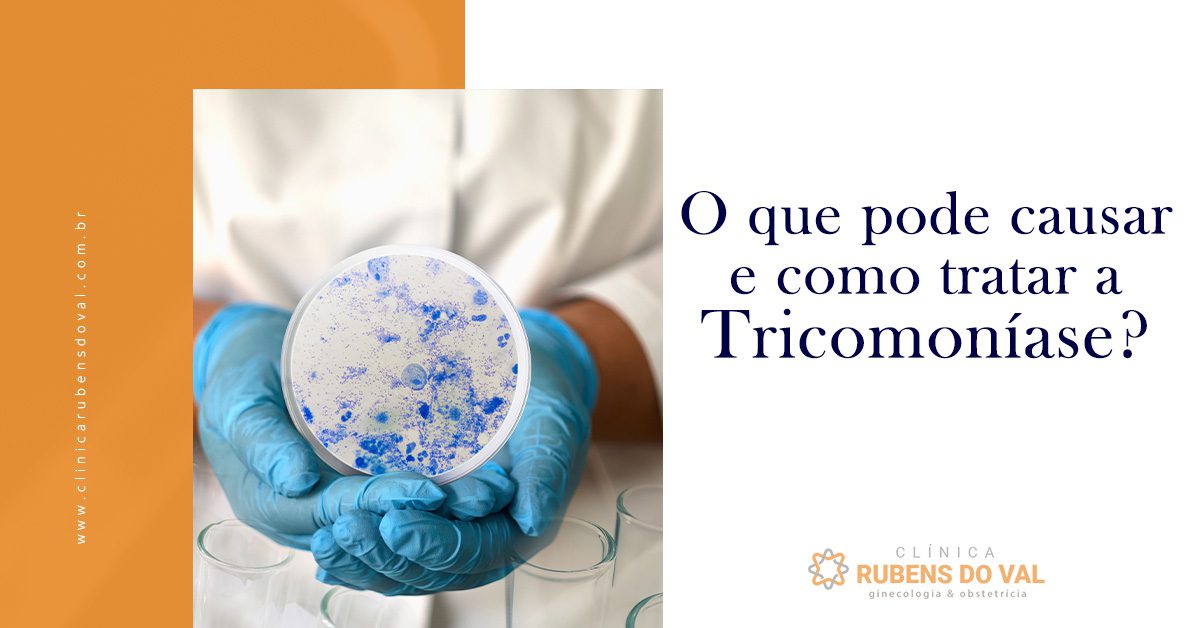
Diagnóstico de Tricomoníase: Exames e Testes Moleculares como o PCR

Vamos combinar, quando o assunto é tricomoniase em homem, muita gente pensa que é coisa só de mulher. A verdade é que o seu corpo pode estar com esse visitante indesejado e você nem imagina. Muitos homens sequer sentem algo, o que é um perigo danado. Mas calma, a gente vai desmistificar isso agora e te mostrar o que você precisa saber para ficar longe dessa encrenca. Preparei um guia direto ao ponto, sem enrolação, para você entender tudo.
O Que Realmente É a Tricomoníase e Por Que Ela Se Torna Invisível nos Homens?
Olha só, a tricomoníase é causada por um parasita minúsculo chamado *Trichomonas vaginalis*. Ele adora o ambiente úmido das nossas partes íntimas.
Para muitos homens, a infecção age como um espião: silenciosa e discreta. Você pode carregar o parasita sem sentir nenhum sintoma aparente, mas ainda assim transmiti-lo.
Essa falta de sinalização é o que torna a tricomoníase em homem um desafio. Ela pode passar despercebida por semanas, meses ou até anos, enquanto o parasita continua ali.
“A tricomoníase em homens é uma Infecção Sexualmente Transmissível (IST) causada pelo protozoário Trichomonas vaginalis. Na maioria dos casos, a infecção é assintomática no público masculino, o que facilita a transmissão silenciosa para parceiros(as).”
Tricomoníase em Homens: O Sintoma Silencioso que Você Ignora

Vamos combinar, quando o assunto é saúde sexual, a gente tende a pensar mais nas mulheres, né? Mas a verdade é que os homens também são alvos de infecções que, muitas vezes, passam despercebidas. E a tricomoníase é uma delas. Pode confessar, você já ouviu falar? Provavelmente sim, mas talvez não saiba que ela pode ser um problema sério também para o público masculino, e o pior: muitas vezes sem dar a menor pista.
Essa IST, causada por um protozoário chamado Trichomonas vaginalis, é mais comum do que a gente imagina. E o que mais pega é que, no caso dos homens, os sintomas podem ser tão discretos que a infecção segue seu curso sem ser notada. Isso abre a porta para uma série de complicações que poderiam ser facilmente evitadas com um pouco mais de atenção.

Neste guia definitivo, vamos desmistificar a tricomoníase em homens. Você vai entender o que é, como ela se manifesta (ou não!), como diagnosticar, tratar e, o mais importante, como se proteger. Prepare-se para ter o controle da sua saúde sexual nas mãos!
| Característica | Detalhe |
|---|---|
| Agente Causador | Protozoário flagelado: Trichomonas vaginalis |
| Transmissão | Relação sexual desprotegida |
| Sintomas Comuns (quando presentes) | Irritação, ardor ao urinar, corrimento uretral discreto |
| Diagnóstico em Homens | Exame de PCL (teste molecular), exame de urina ou secreção |
| Tratamento Principal | Antibiótico (ex: Metronidazol) |
| Prevenção | Uso de preservativo |
| Complicações Potenciais | Inflamação da próstata, epididimite, risco de infertilidade |
O que é Tricomoníase em Homens?
Olha só, a tricomoníase é uma Infecção Sexualmente Transmissível (IST) causada por um parasita microscópico, o Trichomonas vaginalis. Ele adora viver nas vias urinárias e genitais. Enquanto nas mulheres os sintomas costumam ser mais evidentes – como corrimento amarelado, coceira e ardência –, nos homens a história muda de figura. Muitas vezes, o parasita se instala e vive ali tranquilamente, sem dar nenhum sinal.

Isso não quer dizer que ele não esteja causando nenhum mal. Mesmo sem sintomas, o homem pode transmitir a infecção para suas parceiras e, internamente, o protozoário pode estar gerando inflamações. A ausência de sintomas é justamente o que torna a tricomoníase em homens um ‘sintoma silencioso’ e, por isso, tão perigoso. A gente ignora aquilo que não vê, né?
Sintomas da Tricomoníase Masculina
Pode confessar, você está curioso para saber se tem ou não tem. A verdade é que a maioria dos homens infectados com Trichomonas vaginalis não apresenta sintoma algum. É o famoso ‘assintomático’. Mas, quando os sinais aparecem, geralmente são sutis e podem ser confundidos com outras infecções urinárias ou genitais. Fique atento a:

- Leve irritação ou coceira na uretra (o canal por onde sai a urina).
- Sensação de ardor ao urinar, especialmente no final.
- Um corrimento uretral discreto, que pode ser claro, esbranquiçado ou amarelado, e geralmente aparece pela manhã.
- Às vezes, uma leve dor durante a ejaculação.
Esses sintomas podem aparecer alguns dias após a infecção ou demorar semanas. E, como são leves, muita gente simplesmente ignora, achando que é algo passageiro ou sem importância. É aí que o perigo mora!
Como é feito o Diagnóstico da Tricomoníase em Homens?
Diagnosticar a tricomoníase em homens pode ser um desafio justamente pela falta de sintomas claros. Mas a medicina evoluiu e hoje temos ferramentas precisas. O médico pode solicitar:

1. Exame direto da secreção uretral: Uma amostra da secreção do pênis é coletada e examinada ao microscópio. Às vezes, o próprio médico consegue identificar o parasita em movimento.
2. Cultura: A amostra pode ser enviada a um laboratório para tentar cultivar o parasita, o que aumenta a chance de detecção.

3. Teste de PCR (Reação em Cadeia da Polimerase): Este é um método molecular super sensível e específico, considerado um dos mais modernos para detectar o DNA do Trichomonas vaginalis. É a tecnologia que dá o diagnóstico com alta precisão, mesmo com pouquíssima carga parasitária. Um diagnóstico por PCR é a sua melhor aposta para ter certeza.
4. Exame de urina: Em alguns casos, o parasita pode ser detectado na primeira urina da manhã.

A recomendação é procurar um médico urologista ou infectologista se você tiver qualquer suspeita ou se sua parceira for diagnosticada com tricomoníase. Não deixe para depois!
Opções de Tratamento para Tricomoníase
Se o diagnóstico for positivo, não se desespere! A tricomoníase tem tratamento e ele é bastante eficaz. O principal aliado é um antibiótico específico, sendo o Metronidazol o mais comum. Ele geralmente é administrado em dose única, o que facilita muito o cumprimento do tratamento.

Em alguns casos, o médico pode prescrever um esquema com doses diárias por alguns dias, dependendo da sua condição e da gravidade da infecção. É fundamental seguir à risca a prescrição médica, mesmo que os sintomas já tenham desaparecido. Interromper o tratamento antes da hora pode levar à resistência do parasita e dificultar futuras curas.
Lembre-se: a automedicação é perigosa. Apenas um profissional de saúde pode indicar o medicamento e a dosagem correta para o seu caso. Um bom remédio para tricomoníase masculina é aquele prescrito por um médico.

A Importância do Tratamento do Parceiro na Tricomoníase
Aqui está um ponto crucial que muita gente esquece: se você foi diagnosticado com tricomoníase, sua parceira (ou parceiro) sexual também precisa ser tratada, mesmo que ela não apresente sintomas. E vice-versa! Esse é o famoso efeito ‘pingue-pongue’, onde um reinfeta o outro repetidamente, tornando a cura uma batalha sem fim.
O tratamento do parceiro é fundamental para quebrar o ciclo de transmissão e garantir a cura definitiva para ambos. Se a sua parceira for diagnosticada, ela também deve procurar um médico para iniciar o tratamento adequado. É um ato de cuidado consigo mesmo e com quem você se relaciona.
Prevenção da Tricomoníase: Medidas Essenciais
A melhor forma de lidar com qualquer IST é, sem dúvida, a prevenção. E, no caso da tricomoníase, as medidas são bem claras e eficazes. A principal delas é o uso consistente e correto do preservativo em todas as relações sexuais (vaginal, anal e oral).
A prevenção com preservativo é a sua maior aliada não só contra a tricomoníase, mas contra diversas outras ISTs, como clamídia, gonorreia, sífilis, HIV e HPV. É um método simples, acessível e que protege você e seu/sua parceiro(a).

Além disso, ter um diálogo aberto sobre saúde sexual com seus parceiros e manter um acompanhamento médico regular, fazendo exames de rotina, são atitudes inteligentes para manter a saúde em dia.
Riscos e Complicações da Tricomoníase Não Tratada
Como falamos, a tricomoníase pode ser silenciosa, mas isso não a torna inofensiva. Quando não tratada, ela pode trazer uma série de complicações para a saúde masculina. Uma das mais preocupantes é o risco de infertilidade. Isso mesmo! A inflamação crônica causada pelo parasita pode afetar os espermatozoides e, em casos mais graves, levar à dificuldade de ter filhos.

Outras complicações incluem:
- Prostatite: Inflamação da próstata.
- Epididimite: Inflamação do epidídimo, estrutura responsável pelo armazenamento e transporte dos espermatozoides.
- Aumento do risco de contrair HIV: A infecção por tricomoníase pode facilitar a entrada do vírus HIV no organismo.
- Complicações na gravidez: Se o homem transmitir a infecção para uma parceira grávida, pode haver complicações como parto prematuro e baixo peso ao nascer.
Ignorar a tricomoníase é, na verdade, um risco desnecessário. Cuidar da sua saúde sexual é cuidar do seu futuro.

Dúvidas Frequentes sobre Tricomoníase Masculina
A tricomoníase em homens sempre tem sintomas? Não. A maioria dos homens infectados não apresenta sintomas, o que a torna uma IST silenciosa.
Posso pegar tricomoníase usando camisinha? O uso correto de preservativo é a forma mais eficaz de prevenção. Ele reduz drasticamente o risco, mas não é 100% garantido em todos os casos de ISTs.

Quanto tempo demora para os sintomas aparecerem? Se aparecerem, geralmente variam de 5 a 28 dias após a infecção, mas podem demorar mais.
O que acontece se eu não tratar a tricomoníase? Você pode desenvolver complicações como prostatite, epididimite e até mesmo ter o risco de infertilidade aumentado, além de continuar transmitindo a infecção.

Existe remédio natural para curar tricomoníase? Não há comprovação científica de que remédios naturais curem a tricomoníase. O tratamento deve ser feito com antibióticos prescritos por um médico.
Tricomoníase em Homens: Vale a Pena Se Cuidar?
Olha, a resposta é um sonoro SIM! A gente sabe que falar de ISTs ainda carrega um certo tabu, mas é fundamental encarar a realidade: a tricomoníase em homens é uma questão de saúde pública e, mais importante, de saúde pessoal.

O tratamento para tricomoníase é relativamente simples e eficaz, principalmente quando diagnosticado precocemente. As complicações de não tratar, como o risco de infertilidade e inflamações crônicas, são muito mais graves e podem ter um impacto duradouro na sua qualidade de vida.
Portanto, não ignore os sinais, mesmo que sutis. Mantenha um diálogo aberto com seus parceiros, use proteção e, na menor dúvida, procure um médico. Cuidar da sua saúde sexual é um ato de responsabilidade e inteligência. A sua saúde agradece, e o seu futuro também!
Dicas Extras
- Fique atento aos sinais: Mesmo que sutis, o ardor ao urinar e um corrimento discreto podem ser indicativos. Não ignore!
- Comunique-se com seu parceiro(a): A tricomoníase é uma IST. O tratamento simultâneo é crucial para evitar o ‘efeito pingue-pongue’ e garantir a cura de ambos.
- Higiene é importante, mas não é tudo: Manter uma boa higiene íntima ajuda, mas a prevenção real contra a tricomoníase em homens passa pelo uso consistente do preservativo.
- Considere o diagnóstico por PCR: Para uma detecção mais precisa e rápida, especialmente em casos assintomáticos, o teste molecular como o PCR pode ser um grande aliado. Consulte seu médico.
Dúvidas Frequentes
A tricomoníase em homens sempre apresenta sintomas?
Não, a verdade é que a tricomoníase masculina é frequentemente assintomática. Muitos homens não apresentam nenhum sinal da infecção, o que facilita a sua transmissão sem que eles saibam. Por isso, a atenção e a prevenção são fundamentais.
Como é feito o diagnóstico de tricomoníase em homens?
O diagnóstico pode ser feito através da análise de uma amostra de urina ou secreção uretral. Testes moleculares como o PCR têm se mostrado bastante eficazes para identificar a presença do parasita em homens, mesmo quando os sintomas são inexistentes.
Qual o melhor remédio para tricomoníase masculina?
Geralmente, o tratamento para tricomoníase masculina envolve o uso de antibióticos específicos, como o Metronidazol ou Tinidazol, muitas vezes em dose única. É essencial que o médico prescreva o medicamento correto e a dosagem adequada. Lembre-se: nunca se automedique!
O Fim da Ignorância: Proteja-se da Tricomoníase
Olha só, a gente sabe que falar sobre ISTs pode ser desconfortável, mas a verdade é que a informação é a nossa maior arma. A tricomoníase em homens, especialmente quando assintomática, pode passar despercebida e trazer consequências sérias. Não deixe que isso aconteça com você. Converse abertamente com seu(sua) parceiro(a), use o preservativo e, na menor dúvida, procure um médico. Entender sobre o diagnóstico de tricomoníase e os riscos de complicações da tricomoníase não tratada é o primeiro passo para uma vida sexual mais segura e saudável. Cuide-se!

